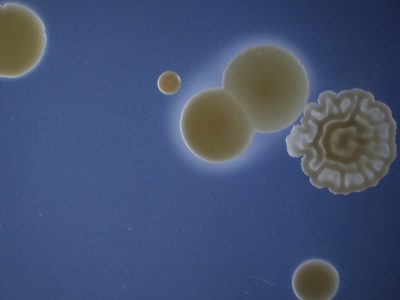
OLYMPUS DIGITAL CAMERA

Aislamiento planetario
Publicada el 22/01/2026
Título: Aislamiento planetario
Autor: Rachel Serrano Bacallao
Av. del Conocimiento 34, Parque Tecnológico Ciencias de la Salud,18016, Granada
Descripción: Levaduras aisladas de la rizosfera de Triticum sp. procedente de Montefrío, crecidas en medio sólido HAGEM, donde formaron colonias globosas, similares a los planetas del sistema solar. La foto fue tomada con una lupa LEICA MZ16 asociada a cámara OLYMPUS DP20.